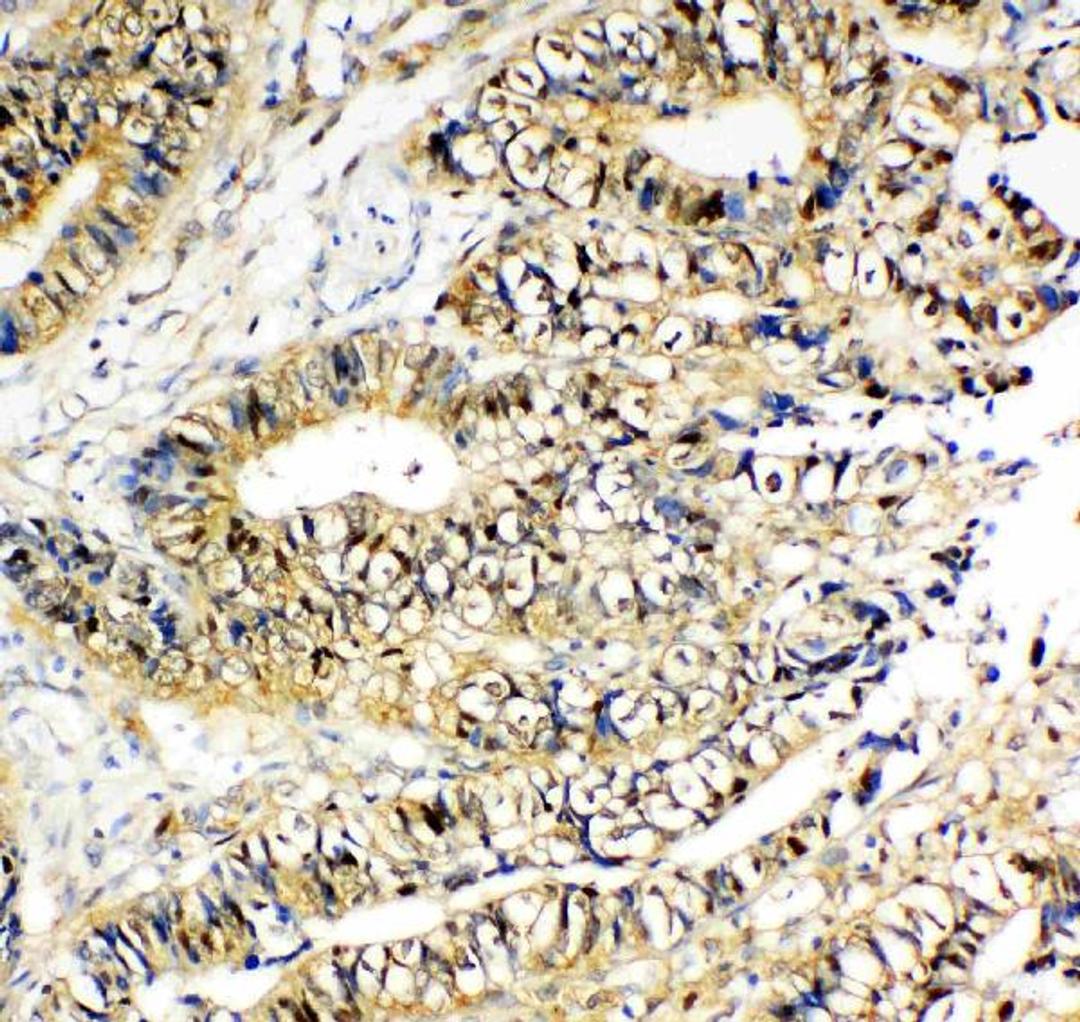
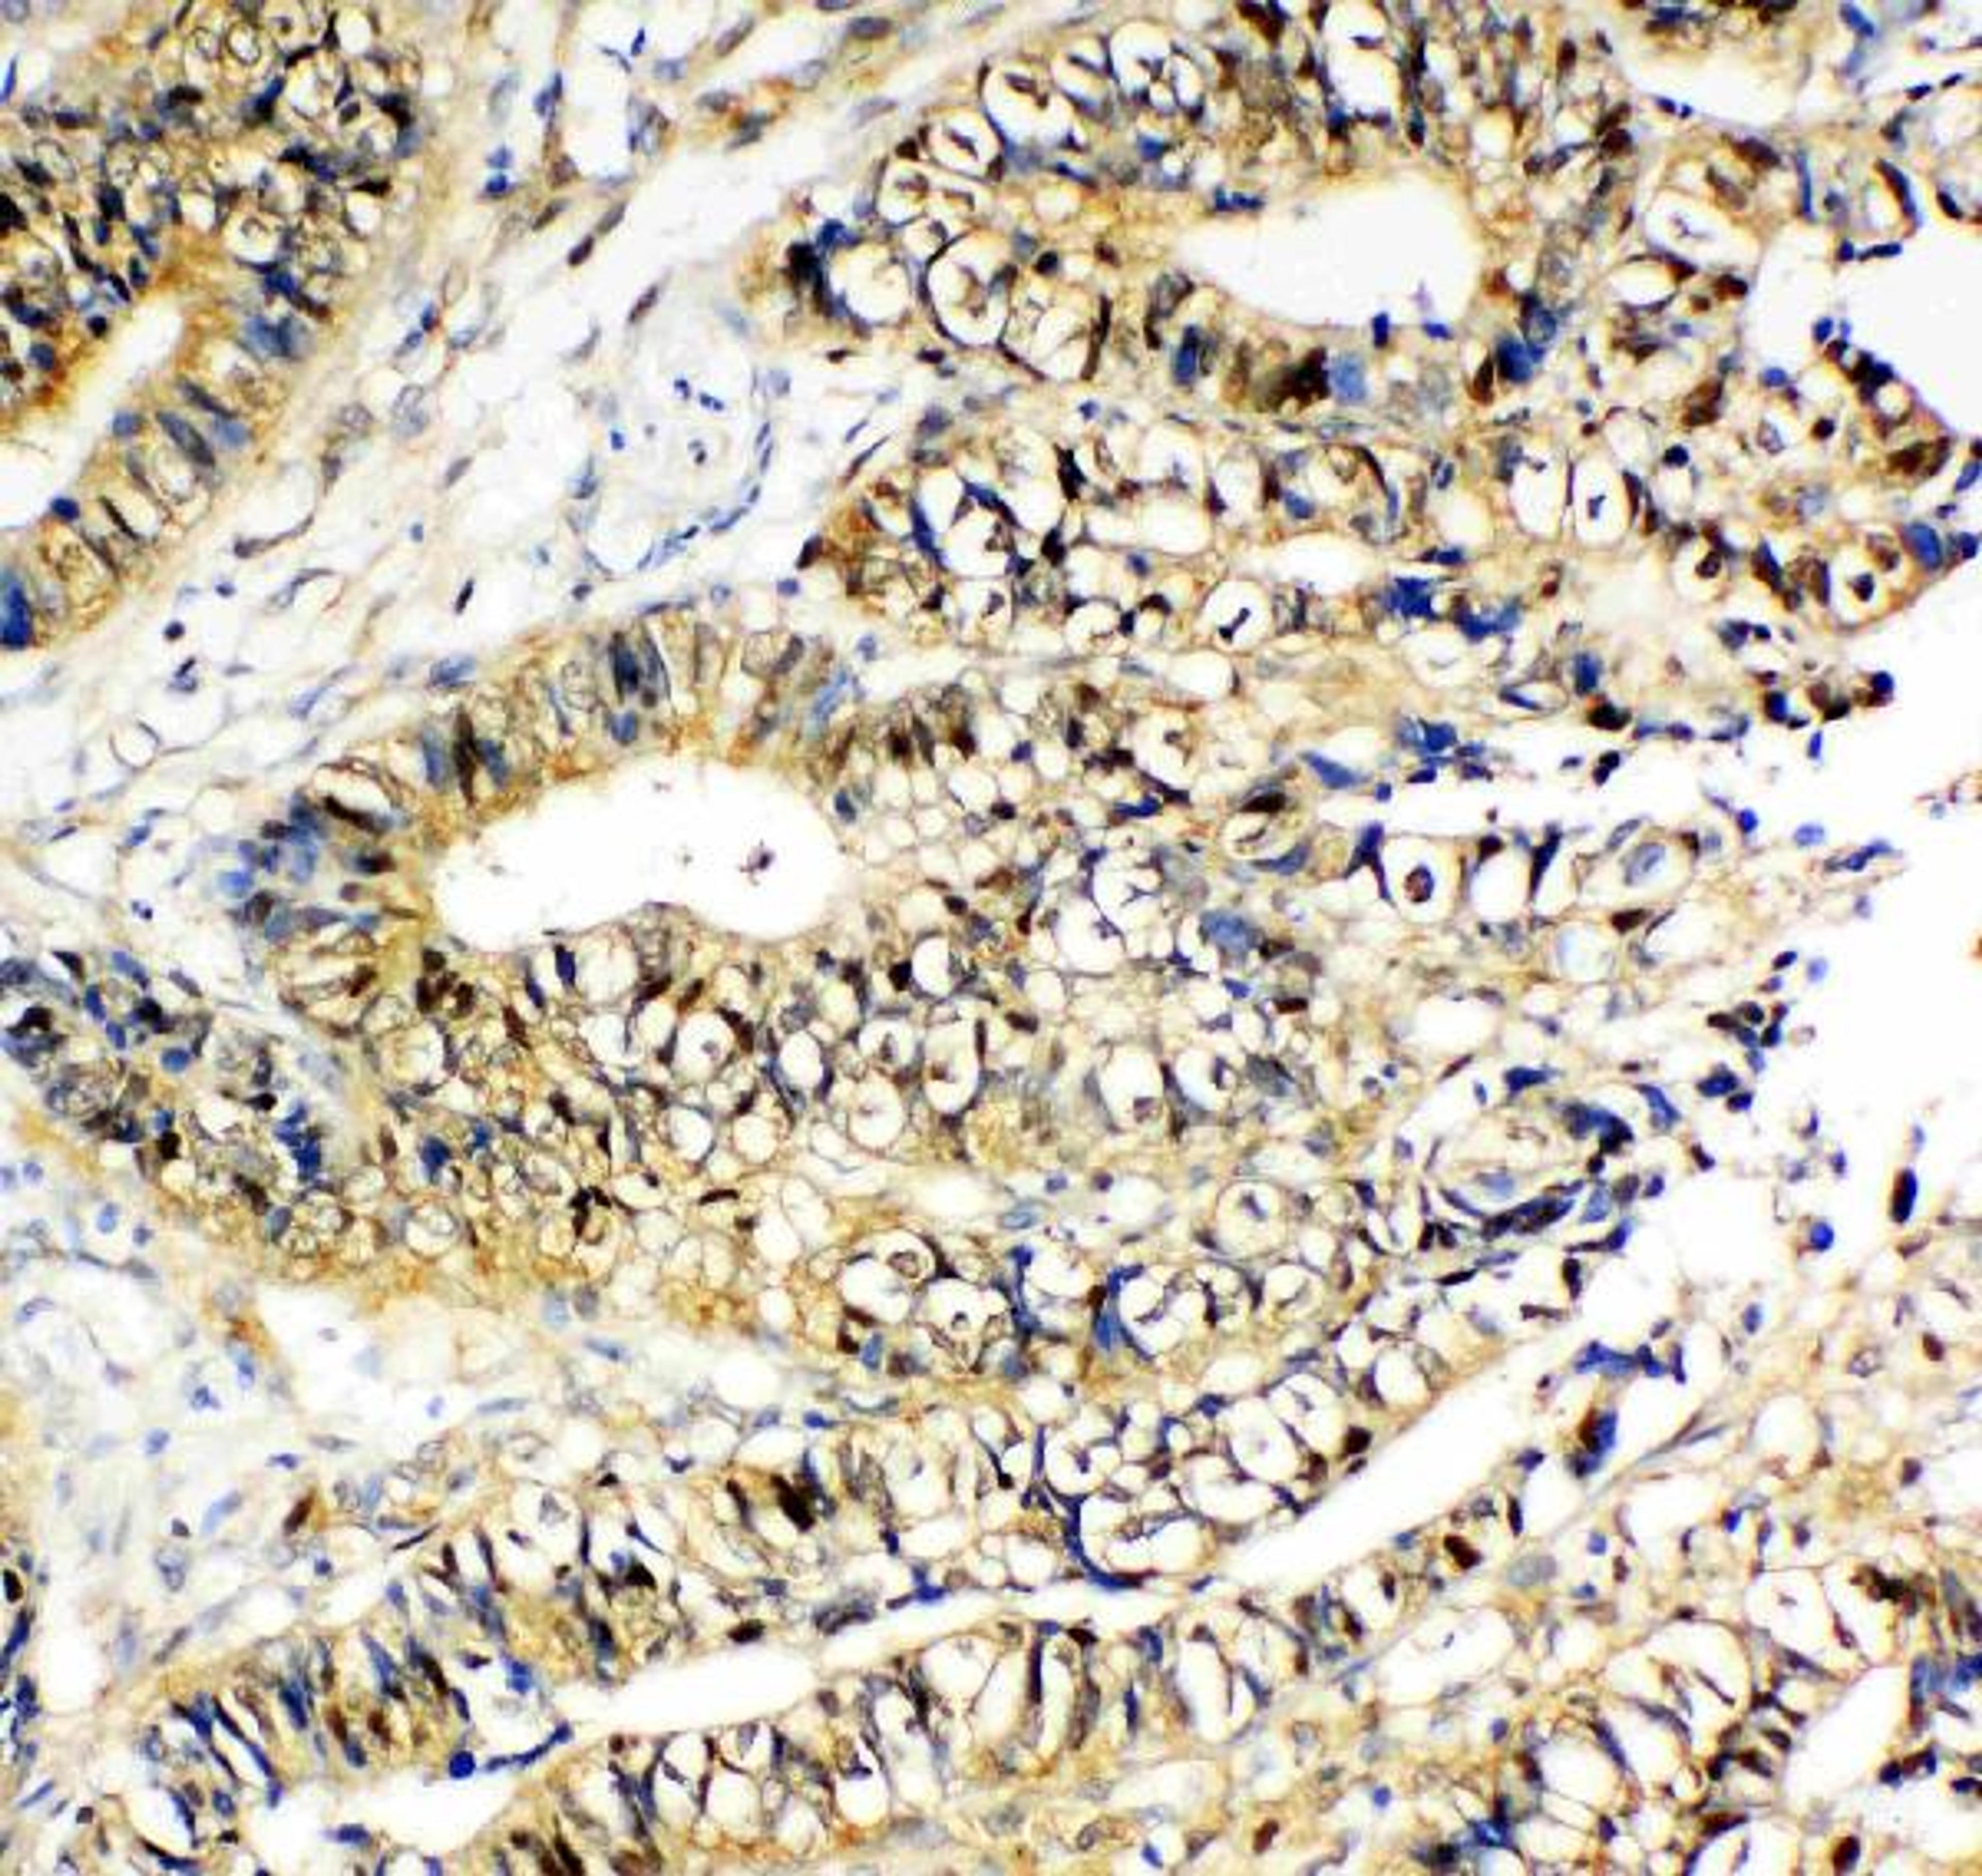

Product & ReviewsAntibodies
Anti-NME2 Antibody
Boster Bio Anti-NME2 Antibody catalog # PA1830. Tested in Flow Cytometry, IF, IHC, ICC, WB applications. This antibody reacts with Human, Mouse, Rat.
Product Details
- Cat. No.
- PA1830
- Type
- Primary Antibody
- Clonality
- Polyclonal
- Host
- Rabbit

The supplier does not provide quotations for this antibody through SelectScience. You can search for similar antibodies in our Antibody Directory.
Reviews
Applications
Antibody Overview
About the company

Boster Bio
Focused on producing well-validated antibodies and ELISA kits